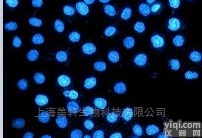
<em>细胞</em>Hoechst<em>凋亡</em>染色

| Enzo 活细胞产品 |
| 货号 | 名称 | 用途 |
| ALX-850-020-KI01 | Annexin V-FITC apoptosis detection kit | 细胞膜介导的凋亡检测 |
| ALX-850-020-KI02 | Annexin V-FITC apoptosis detection kit | 细胞膜介导的凋亡检测 |
| ENZ-51002-100 | GFP CERTIFIEDTM Apoptosis/Necrosis Detection Kit | 细胞膜介导的凋亡检测 |
| ENZ-51002-25 | GFP CERTIFIED TM Apoptosis/Necrosis Detection Kit | 细胞膜介导的凋亡检测 |
| ENZ-51021-K200 | NUCLEAR-ID ® Green Chromatin | 凋亡检测 |
| ENZ-51031-0050 | CYTO-ID ® Autophagy Detection Kit | 自噬检测 |
| ENZ-51031-K200 | CYTO-ID ® Autophagy Detection Kit | 自噬检测 |
| ENZ-53004-C100 | NUCLEAR-ID ® Blue/Green Cell | 活/死细胞区分 |
| ENZ-53005-C100 | NUCLEAR-ID ® Blue/Red cell viability reagent | 活/死细胞区分 |
| ENZ-53006-C100 | NUCLEAR-ID ® Red/Green Cell | 活/死细胞区分 |
| ENZ-51006-500 | TOTAL-NUCLEAR-ID ® Green/Red | 细胞核和核仁同时染色 |
| ENZ-51009-500 | NUCLEOLAR-ID TM Green Detection Kit | 核仁检测 |
| ENZ-CHM103 | NUCLEAR-ID ® Blue DNA stain (GFP CERTIFIED®) | DNA染料 |
| ENZ-KIT130-0010 | Cellular senescence live cell analysis assay | 细胞衰老检测 |
| ENZ-51008-100 | NUCLEAR-ID ® Red Cell Cycle | 细胞周期检测 |
| ENZ-51014-100 | NUCLEAR-ID ® Green Cell Cycle | 细胞周期检测 |
| ENZ-51036-K025 | CYTO-ID ® Green long-term cell tracer kit | 长期细胞示踪 |
| ENZ-51037-K025 | CYTO-ID ® Red long-term cell tracer kit | 长期细胞示踪 |
| ENZ-51032-K100 | ORGANELLE-ID-RGB TM III Assay Kit | 多细胞器染色 |
| ENZ-53007-C200 | ORGANELLE-ID-RGB® reagent I | 多细胞器染色 |
| ENZ-53008-C200 | ORGANELLE-ID-RGB® reagent II | 多细胞器染色 |
| ENZ-53009-C200 | ORGANELLE-ID-RGB® reagent IV for microscopy | 多细胞器染色 |
| ENZ-51005-0100 | LYSO-ID® Red detection kit (GFP CERTIFIED®) for microscopy | 溶酶体检测 |
| ENZ-51005-500 | LYSO-ID ® Red Detection Kit (GFP CERTIFIED TM | 溶酶体检测 |
| ENZ-51034-0100 | LYSO-ID® Green detection kit for microscopy | 溶酶体检测 |
| ENZ-51034-K500 | LYSO-ID ® Green detection kit for microscopy | 溶酶体检测 |
| ENZ-51015-KP002 | LYSO-ID ® Red Cytoxicity Kit (GFP CERTIFIEDTM | 溶酶体毒性检测试剂盒 |
| ENZ-51007-0100 | MITO-ID® Red detection kit (GFP CERTIFIED®) for microscopy | 线粒体检测 |
| ENZ-51007-500 | MITO-ID TM Red Detection Kit (GFP CertifiedTM) | 线粒体检测 |
| ENZ-51022-0100 | MITO-ID® Green detection kit for fluorescence microscopy | 线粒体检测 |
| ENZ-51022-K500 | MITO-ID TM Green Detection Kit | 线粒体检测 |
| ENZ-51018-0025 | MITO-ID TM Membrane Potential Detection Kit | 线粒体毒性检测试剂盒 |
| ENZ-51018-K100 | MITO-ID TM Membrane Potential Detection Kit | 线粒体毒性检测试剂盒 |
| ENZ-51019-KP002 | MITO-ID TM Membrane Potential Detection Kit | 线粒体毒性检测试剂盒 |
| ENZ-51025-K500 | ER-ID TM Green Assay Kit | 内质网检测 |
| ENZ-51026-K500 | ER-ID TM Red Assay Kit (GFP-Certified TM | 内质网检测 |
| ENZ-51028-K100 | GOLGI IDTM Green Assay Kit | 高尔基体检测 |
| ENZ-51035-0025 | PROTEOSTAT ® Aggresome Detection Kit | 聚集小体检测 |
| ENZ-51035-K100 | PROTEOSTAT ® Aggresome Detection Kit | 聚集小体检测 |
| ENZ-51001-200 | ROS/RNS Detection Kit for Microscopy | 活性氧/活性氮检测 |
| ENZ-51010 | Total ROS/Superoxide detection kit | 活性氧/超氧化物检测 |
| ENZ-51011 | Total ROS Detection Kit | 活性氧检测 |
| ENZ-51013-200 | NO Detection Kit | NO检测 |
| ENZ-51012 | Superoxide Detection kit | 超氧化物检测 |
| ENZ-51042-0125 | CYTO-ID® Hypoxia/Oxidative Stress Detection kit | 组织缺氧检测 |
| ENZ-51042-K500 | CYTO-ID ® Hypoxia/Oxidative Stress Detection Kit | 组织缺氧检测 |
| ENZ-51016 | FLUOFORTE® Calcium assay kit for microplates | 钙离子检测 |
| ENZ-51017 | FLUOFORTETM Calcium Assay Kit for Microplates | 钙离子检测 |
| ENZ-51020-KP010 | GFP CERTIFIEDTM FLUOFORTETM Calcium | 钙离子检测 |
| ENZ-51020-KP100 | GFP CERTIFIEDTM FLUOFORTETM Calcium | 钙离子检测 |
| ENZ-51046 | MITO-ID® Intracellular O2 Sensor Probe | 胞内O2探针 |
| ENZ-51044-K100 | MITO-ID ® Extracellular O2 Sensor kit | 胞外O2检测 (线粒体功能紊乱) |
| ENZ-51044-K500 | MITO-ID ® Extracellular O2 Sensor kit | 胞外O2检测 (线粒体功能紊乱) |
| ENZ-51045-K100 | MITO-ID ® Extracellular O2 Sensor kit | 胞外O2检测 (线粒体功能紊乱) |
| ENZ-51045-K500 | MITO-ID ® Extracellular O2 Sensor kit | 胞外O2检测 (线粒体功能紊乱) |
| ENZ-51048 | MITO-ID® Extracellular pH Sensor Probe | 胞外pH探针 |
| ENZ-51029-K100 | EFLUXX-ID R Green Multi-Drug Resistance Assay Kit | 多药耐药检测 |
| ENZ-51030-K100 | EFLUXX-ID R Gold Multi-Drug Resistance Assay Kit | 多药耐药检测 |
| ENZ-51004 | Red Hydrogen Peroxide Assay Kit for Microplates | 常见细胞分析荧光染料 |
| ENZ-42541 | Cyanine 3-NHS ester pack |
| ENZ-42542 | Cyanine 5-NHS ester pack |
| ENZ-52002 | Calcein AM (ultra pure) |
| ENZ-52003 | Calcein Blue (ultra pure) |
| ENZ-52004 | Fluo-3 AM (ultra pure) |
| ENZ-52006 | FURA-2 AM (ultra pure) |
| ENZ-52007 | FURA-2 (ultra pure) |
| ENZ-52008 | INDO-1 AM (ultra pure) |
| ENZ-52010 | Rhod-2 AM (ultra pure) |
| ENZ-52013 | Quin-2 (ultra pure) |
| ENZ-52051 | 5-Carboxyfluorescein (ultra pure) |
| ENZ-52054 | Coelenterazine (ultra pure) |
| ENZ-52102 | BCECF AM (ultra pure) |
| ENZ-52103 | 5(6)-CDCFDA (ultra pure) |
| ENZ-52104 | CFDA (ultra pure) |
| ENZ-52151 | Zinquin ethyl ester (ultra pure) |
| ENZ-52152 | Zinquin free acid (ultra pure) |
| ENZ-52153 | TSQ (ultra pure) |
| ENZ-52154 | Lucigenin (ultra pure) |
| ENZ-52156 | MQAE (ultra pure) |
| ENZ-52201 | Di-2-ANEPEQ |
| ENZ-52204 | Di-8-ANEPPS |
| ENZ-52205 | DIBAC4(3) (ultra pure) |
| ENZ-52207 | DilC1(5) iodide (ultra pure) |
| ENZ-52251 | MM 1-43 |
| ENZ-52252 | MM 4-64 |
| ENZ-52253 | Hydroxystilbamidine (ultra pure) |
| ENZ-52302 | Dihydrorhodamine 123 (ultra pure) |
| ENZ-52303 | DiOC6(3) iodide (ultra pure) |
| ENZ-52304 | JC-1 (ultra pure) |
| ENZ-52306 | NAO (ultra pure) |
| ENZ-52307 | Rhodamine 123 (ultra pure) |
| ENZ-52309 | TMRE (ultra pure) |
| ENZ-52354 | Luminol (ultra pure) |
| ENZ-52401 | Hoechst 33342 (ultra pure) |
| ENZ-52402 | Hoechst 33258 (ultra pure) |
| ENZ-52403 | Propidium Iodide (ultra pure) |
| ENZ-52404 | DAPI (ultra pure) |
| ENZ-52405 | Acridine Orange (ultra pure) |
| ENZ-52406 | NUCLEAR-ID(R) Red DNA Stain |
| ENZ-52451 | 5-FITC (ultra pure) |
| ENZ-52455 | Dansyl chloride (ultra pure) |
| ENZ-52456 | NBD-Cl (ultra pure) |
| ENZ-52501 | Monobromobimane (ultra pure) |
| ENZ-52502 | Fluorescein-5-maleimide (ultra pure) |
| ENZ-52542 | Fluorescein-5-maleimide (ultra pure) |
| ENZ-52551 | Nile Red (ultra pure) |
| ENZ-52552 | Congo Red (ultra pure) |